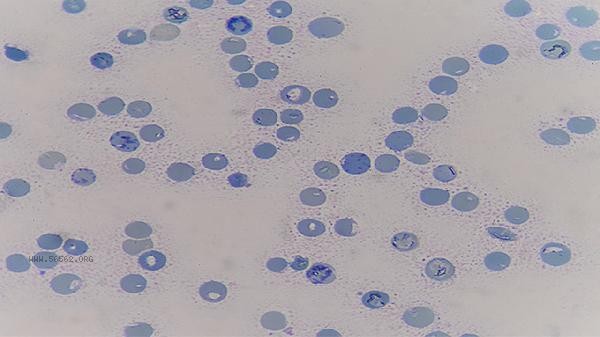

The high level of female lymphocytes may be related to viral infection, bacterial infection, blood system diseases, autoimmune diseases, endocrine diseases, etc. Common diseases include infectious mononucleosis, tuberculosis, chronic lymphocytic leukemia, systemic lupus erythematosus, hyperthyroidism, etc. Lymphocytes are an important component of the immune system, and their numerical abnormalities need to be comprehensively judged in conjunction with other examinations.

1. Infectious mononucleosis
Infectious mononucleosis is mainly caused by EB virus infection, manifested as fever, sore throat, lymph node enlargement, and elevated absolute value and proportion of lymphocytes in blood routine examination. The treatment is mainly based on symptomatic support, and antiviral drugs such as acyclovir tablets and ganciclovir capsules can be used according to medical advice. When fever occurs, ibuprofen sustained-release capsules can be used in combination to reduce fever.
2. tuberculosis
Mycobacterium tuberculosis infection may lead to increased lymphocyte reactivity, accompanied by cough, night sweat, emaciation and other symptoms. Diagnosis needs to be confirmed through tuberculin test, chest CT, etc. Treatment requires standardized use of anti tuberculosis drugs such as isoniazid tablets and rifampicin capsules, and the course of treatment usually takes more than 6 months.
3. Chronic lymphocytic leukemia
Chronic lymphocytic leukemia is a clonal proliferative disease of B lymphocytes, commonly seen in middle-aged and elderly women, characterized by sustained increase in lymphocytes and lymph node enlargement. Diagnosis requires bone marrow puncture examination, and chemotherapy drugs such as phenylbutyrate nitrogen mustard tablets and fludarabine injection can be used for treatment. If necessary, targeted therapy may be combined with rituximab injection. Systemic lupus erythematosus (SLE) caused by autoimmune abnormalities can lead to lymphocyte activation and proliferation, with typical symptoms including facial butterfly erythema and joint pain. Diagnosis should be combined with anti nuclear antibody testing. Treatment commonly uses acetate prednisolone tablets and hydroxychloroquine sulfate tablets to regulate immunity. In severe cases, cyclophosphamide injection should be used.

5. Hyperthyroidism
Excessive secretion of thyroid hormones may stimulate lymphocyte proliferation, accompanied by palpitations, excessive sweating, and weight loss in patients. Diagnosis can be confirmed through thyroid function examination, and the preferred treatment is methimazole tablets to inhibit thyroid hormone synthesis. For those with fast heart rate, propranolol hydrochloride tablets can be added to control symptoms. When lymphocytes are found to be high, it is recommended to recheck the blood routine and complete peripheral blood smear, virus antibody testing, autoantibody screening and other tests. It is necessary to ensure sufficient sleep in daily life, avoid overwork, and supplement vitamin C and high-quality protein in moderation to enhance immunity. If accompanied by symptoms such as persistent fever, sudden weight loss, or lymph node enlargement, it is necessary to seek medical attention promptly at a hematology or immunology department to avoid self medication delaying the condition.
Comments (0)
Leave a Comment
No comments yet
Be the first to share your thoughts!